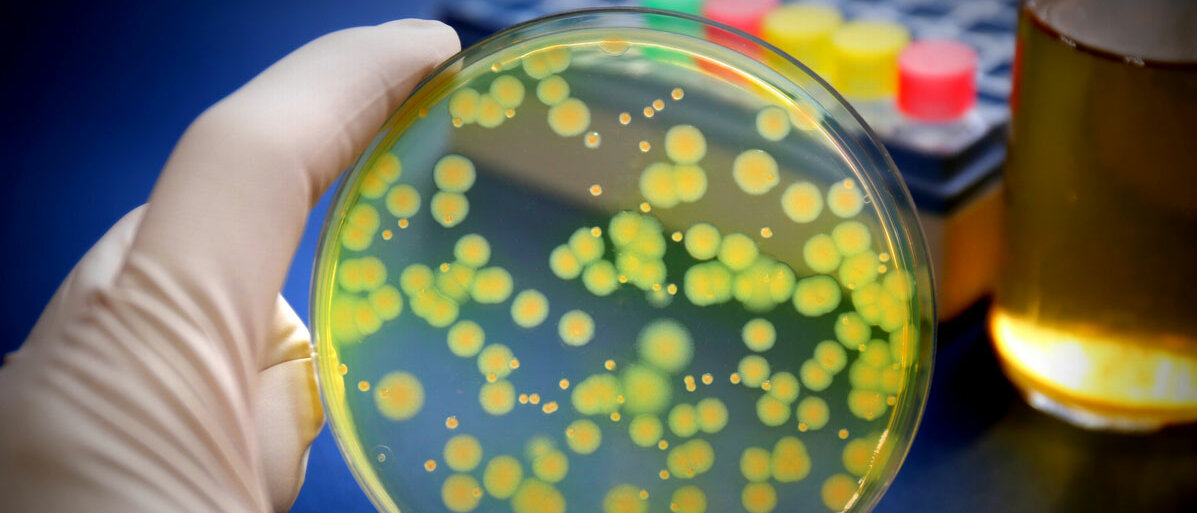

Antibiotikaentwicklung
NEUER WIRKSTOFF IM KAMPF GEGEN RESISTENTE KEIME
Seite 1/1 2 Minuten
Lungenentzündungen, Wund-, Augen- und Harnwegsinfektionen, Sepsis – die Infektionskrankheiten gehen alle auf das Konto von Pseudomonas aeruginosa. Das gramnegative Stäbchenbakterium gilt als ausgesprochen anspruchslos und somit lange überlebensfähig. Vor allem feuchte Umgebungen ziehen den Keim an: Waschbecken, Inkubatoren, Blumenvasen, Seifenspender oder Beatmungsschläuche.
Vor allem letzteres birgt ein großes Risiko für Intensivpatient*innen, die vorbelastet durch Covid-19 oder Mukoviszidose besonders anfällig für eine Infektion sind. Eine zusätzliche Lungenentzündung, ausgelöst durch Pseudomonas aeruginosa, kann schnell zum Todesurteil werden. Das größte Problem dabei: Bei etwa zehn Prozent der Infektionen mit dem Problemkeim liegen Resistenzen gegen drei oder mehr Antibiotikaklassen vor. Man erwartet, dass die Resistenzlage sich in den nächsten Jahren noch verschärfen wird.
„Pathoblocker“ macht P. aeruginosa unschädlich
Nicht immer ist abtöten die passende Strategie. Das Team um Professorin Anna Hirsch vom Helmholtz-Institut für Pharmazeutische Forschung Saarland (HIPS) verfolgte einen anderen Ansatz. Sie schalteten ein bestimmtes Enzym des Bakteriums aus, das es ihm ermöglicht, menschliches Gewebe abzubauen und so den eigentlichen Infektionsort zu erreichen. Bei LasB oder Pseudomonas-Elastase (Pseudolysin) handelt es sich um eine Metalloprotease, deren Schlüsselfunktion während des Infektionsgeschehens bereits wissenschaftlich bekannt ist. Anna Hirsch, Leiterin der Abteilung Wirkstoffdesign und Optimierung am HIPS, sagt: „Da uns die dreidimensionale Molekülstruktur von LasB aus einer früheren Studie bestens bekannt war, konnten wir unsere Moleküle so entwerfen, dass sie bestmöglich zu ihrem Zielprotein passen und dieses effizient und spezifisch inaktivieren können. Das Ergebnis ist eine Reihe an Wirkstoffkandidaten, die dazu in der Lage sind, LasB 12-mal besser zu binden als bisherige Kandidaten. Das ist ein ausgezeichneter Ausgangspunkt für die weitere Entwicklung hin zum fertigen Medikament.“ Dabei wird das Bakterium nicht abgetötet, sondern lediglich in seiner Infektiösität blockiert – sozusagen unschädlich gemacht. Die neue Wirkstoffklasse konnte sich bereits an Untersuchungen mit Larven beweisen.
Innovativer Ansatz mit Weitblick
Einfach immer neue Antibiotika zu entwickeln, ändert auf lange Sicht nichts am grundlegenden Problem der Resistenzbildung. Die sogenannten Pathoblocker, die das Bakterium lediglich unschädlich machen und nicht abtöten, verhindern eine schnelle Mutation und damit die Ausbildung weiterer Resistenzen. Prof. Rolf Müller, Geschäftsführender Direktor des HIPS und Leiter der Abteilung Mikrobielle Naturstoffe, bewertet den Ansatz als sinnvolle Ergänzung zur Entwicklung neuer antibiotischer Wirkstoffe: „Leider ist die Entwicklung neuer Antibiotika sehr langwierig, teuer und wird nur noch von wenigen Pharmafirmen unterstützt. Die entwickelten Substanzen bieten uns einen alternativen Ansatz, um das Problem der antimikrobiellen Resistenz angehen zu können. Da sich resistente Keime auch in Zukunft immer mehr ausbreiten werden, sind solche Wirkstoffkandidaten von unschätzbarem Wert.“ In Folgestudien muss der Kandidat sich nun an Menschen beweisen.
Quellen:
https://idw-online.de/de/news784102
https://flexikon.doccheck.com/de/Pseudomonas_aeruginosa
https://www.bmglabtech.com/enzyme-kinetic-measurements-for-a-combinatorial-library-of-inhibitors-of-pseudomonas-elastase/